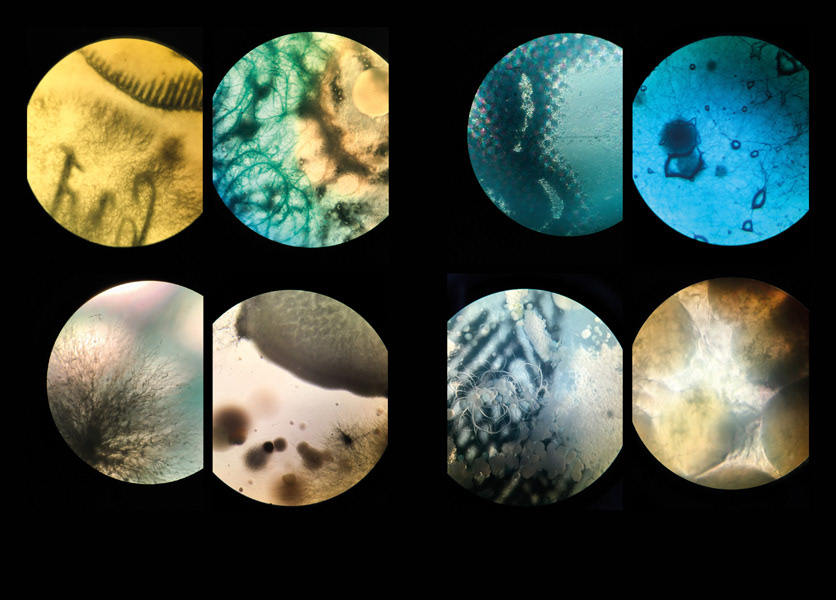
Colonies (Serie). Cultivo de bacterias sobre imagenes del Archivo de Indias. 2017

Exposición Dimensiones Paralelas. (Video documentación) Fundación BilbaoArte Fundazioa, Bilbao - España (Julio - 2017)
Las obras que forman parte de la exposición Dimensiones Paralelas de Cristian Villavicencio, ocupan una zona de frontera, donde las imágenes proyectadas, los objetos registrados y los dispositivos tecnológicos sirven para crear un cuarto lugar entre lo digital, lo analógico y el cuerpo. En ese cuarto lugar se cuestiona el conocimiento, se revelan capas de discursos sociales y preocupaciones sobre la posibilidad de revisión y relectura de la historia de las ciencias, de las instituciones, del arte.
Las excursiones artísticas al campo de las ciencias se han vuelto habituales desde que los artistas empezaron a actuar como investigadores, traspasando las fronteras de la praxis del arte para hurgar -indisciplinadamente- en otras disciplinas. Ese indisciplinamiento es de lo más productivo cuando sirve para poner en tensión los marcos de creación de conocimiento. Eso ocurre en las jornadas de trabajo de Cristian Villavicencio en la reserva del Instituto de Ciencias Biológicas de la Escuela Politécnica Nacional (Ecuador) o en el Archivo General de Indias (España). Los especímenes disecados y las ilustraciones históricas, vistos desde el lente del arte y puestos a girar, sueltan sus registros habituales para empezar a hacernos preguntas sobre los sistemas que hemos creado para mirarlos: ¿de dónde vienen esos sistemas? ¿qué lógicas de colonización de conocimiento los atraviesan?
El trabajo de Cristian Villavicencio usa recursos del media-art para encontrar otros modos de comprender los conceptos de conocimiento, historia, ciencia y archivo. Los zooms a las pieles de los animales, a los huesos fosilizados, a las rocas funcionarían como puertas de acceso a lo desconocido, podrían referirnos a una memoria a la que no tendremos acceso, un tiempo detenido anterior a nuestro tiempo.
*(Texto Anamaría Garzón Mantilla en conversación con Cristian Villavicencio. )

Exposición Dimensiones Paralelas. Fundación BilbaoArte Fundazioa, Bilbao - España

Exposición Dimensiones Paralelas. Fundación BilbaoArte Fundazioa, Bilbao - España

Exposición Dimensiones Paralelas. Fundación BilbaoArte Fundazioa, Bilbao - España

Exposición Dimensiones Paralelas. Fundación BilbaoArte Fundazioa, Bilbao - España

Exposición Dimensiones Paralelas. Fundación BilbaoArte Fundazioa, Bilbao - España

Exposición Dimensiones Paralelas. Fundación BilbaoArte Fundazioa, Bilbao - España

Exposición Dimensiones Paralelas. Fundación BilbaoArte Fundazioa, Bilbao - España

Megatherium. Impresión 3D, Cultivo de Bacterias. 2017

Megatherium. Impresión 3D, Cultivo de Bacterias. 2017

Jardí́n. Plantas aromáticas, microscopio, sistema mecánico. 2017

Jardí́n. Plantas aromáticas, microscopio, sistema mecánico. 2017

Colonies (Serie). Cultivo de bacterias sobre imagenes del Archivo de Indias. 2017
Colonies (Serie). Cultivo de bacterias sobre imagenes del Archivo de Indias. 2017

Colonies (Serie). Impresión Digital sobre Tela. Ventiladores programados. 2017

Colonies (Serie). Impresión Digital sobre Tela. Ventiladores programados. 2017

Especímenes. Video HD - 2 canales. 2017

Métodos y procesos de trabajo
Procesos de trabajo en el proyect artístico en el Instituto de Ciencias Biológicas de la Escuela Politécnica Nacional en Quito- Ecuador, donde se realizaron un serie de vídeos, escaneos en 3D de material histórico y biológico además de entrevistas a investigadores del instituto. A partir de este primer acercamiento se evidenció una relación entre estudios históricos, biológicos y el Media-art.
Este proyecto ha sido realizado gracias el apoyo de:




